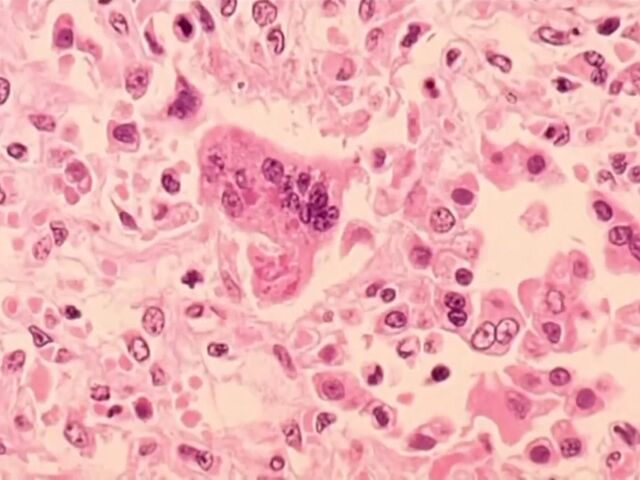

First Measles Case Confirmed in San Diego County in Over Four Years
ICARO Media Group
The patient, a 1-year-old infant, has been hospitalized after recently traveling overseas. The County of San Diego Health and Human Services Agency confirmed the case on Friday.
County Public Health Officer Wilma Wooten issued a statement emphasizing the contagious nature of measles, which can easily spread through coughing, sneezing, or simply being in close proximity with an infected individual. As a result, officials are urging anyone who may have been exposed to be vigilant for symptoms and to contact their healthcare provider if they experience any signs of the disease.
The specific locations where potential exposure may have occurred include Grossmont Pediatrics and Rady Children's Hospital. County health officials are working closely with these institutions to identify and notify both patients and staff who may have come into contact with the infected individual. Super China Buffet is another location where potential exposure could have taken place, and management is cooperating with officials to identify and reach out to staff members.
According to health authorities, symptoms of measles typically appear between seven to 21 days after exposure. Initial signs can include fever, cough, runny nose, and red eyes, followed by the characteristic red rash, which usually appears one to four days after the early symptoms. It is important to note that individuals are considered contagious four days before and four days after the rash develops.
To mitigate the spread of the disease, health officials are urging individuals who develop symptoms to contact their medical provider in advance, rather than arriving unannounced. This precaution allows for the activation of infection control measures to prevent further exposure to others.
In light of this recent case, County Public Health Officer Wilma Wooten stressed the importance of measles vaccination. She recommended that all international travelers receive the measles vaccine, especially considering ongoing outbreaks in several countries. Infants between 6 and 12 months of age who travel should receive one dose, while travelers over 12 months of age should receive two doses, spaced at least four weeks apart.
This marks the first confirmed case of measles in San Diego County since 2019, when two cases were reported. The previous cases involved an unvaccinated infant and a vaccinated individual who had been in contact with the child. County health officials are closely monitoring the situation and working diligently to minimize the impact of the disease within the community.




